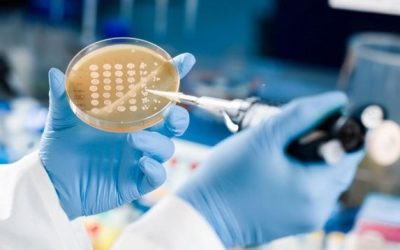
Tres nuevos medicamentos para luchar contra las «superbacterias» resistentes a los antibióticos

Actualidad
¿Necesitas potenciar la formación médica en tu organización?
BioPress | 10.08.2024 En BioPress Formación, somos expertos en e-learning médico y sabemos cómo gestionar de manera integral la formación científica de tu equipo. Contamos con la experiencia, la tecnología y el enfoque pedagógico necesario para...
Cost-Effectiveness Models (Modelos de Costo-Efectividad)
BioPress| 18/08/2024
Investigación : ESTUDIOS RWE
BioPress | 10.08.2024 En BioPress HealthCare, con más de 10 años de experiencia en el mercado, ofrecemos soluciones de alta calidad en investigación clínica, desarrollando e implementando proyectos específicos según las necesidades de nuestros...
Madrid inicia un programa pionero para administrar tratamientos oncológicos en el domicilio
Diego Buenosvinos | 3o.07.2024 La Comunidad de Madrid ha puesto en marcha en el Hospital público Universitario Gregorio Marañón un programa pionero en la región para la administración a domicilio de tratamientos oncológicos. Esta medida, que...
BioPress Healthcare Hace la Ciencia Más Accesible con Nuevos Resúmenes Cientificos en Video
BioPress| 25.07.2024 BioPress Healthcare hace la Ciencia más accesible con Nuevos Resúmenes Cientificos en Video ( R1M ) BioPress, una agencia líder en contenido científico y médico, ahora ofrece a clientes y profesionales de la salud acceso a...
BioPress Healthcare Madrid Lanza Nuevos Servicios y Unidad de Negocio en HEOR/RWE
BioPress| 23.07.2024 BioPress Healthcare, una destacada agencia de comunicación en Economía e Investigación de Resultados en Salud / Evidencia de la Vida Real (HEOR/RWE), anuncia el lanzamiento de una nueva unidad de negocio en Madrid, expandiendo...
Tres nuevos medicamentos para luchar contra las «superbacterias» resistentes a los antibióticos
MÓNICA MORALES| 17.07.2024 Desde el descubrimiento de la penicilina por Alexander Fleming en 1928, los antibióticos han sido una de las herramientas más poderosas en la medicina para combatir infecciones bacterianas. Sin embargo, las bacterias no...
Med Elite Pro ™ : Un programa de formación médica de alto nivel (By BioPress)
BioPress | 18.07.2024 Descripción del curso: Med Elite Pro ™ es un programa de formación médica de alto nivel diseñado para profesionales que buscan la excelencia en su campo. El curso está estructurado en 6 módulos, cada uno de los cuales se...
Survey insights valiosos con nuestro servicio de investigación cuantitativa a través de encuestas
BioPress | 18.07.2024 Presentamos nuestro servicio de investigación cuantitativa a través de encuestas, realizado en colaboración con Vademecum Vidal, la principal fuente de información sanitaria en España. ¿Qué ofrecemos? Acceso a una base de...
Taller de Escritura y Publicación Médica para Jóvenes Médicos
BioPress | 15.07.2024 Índice de Contenido Introducción Importancia de la comunicación escrita en medicina Beneficios de publicar en revistas médicas Oportunidades para jóvenes médicos en la publicación médica Módulo 1: Fundamentos de la escritura...
Emprende en Salud: Crea y Gestiona tu Propia Consulta Médica GINECOLOGICA
BioPress | 15.07.2024 Módulo 1: Introducción al mundo de las consultas médicas 1.1 Importancia de las consultas médicas en el sistema sanitario Rol fundamental de las consultas médicas en la atención primaria y especializada Impacto de las...
Métricas clave para medir el éxito de las campañas publicitarias
BioPress | 10.07.2024 Para evaluar la efectividad de las campañas publicitarias y optimizar el retorno de la inversión (ROI), es fundamental utilizar métricas relevantes que proporcionen información precisa sobre el desempeño de las acciones...